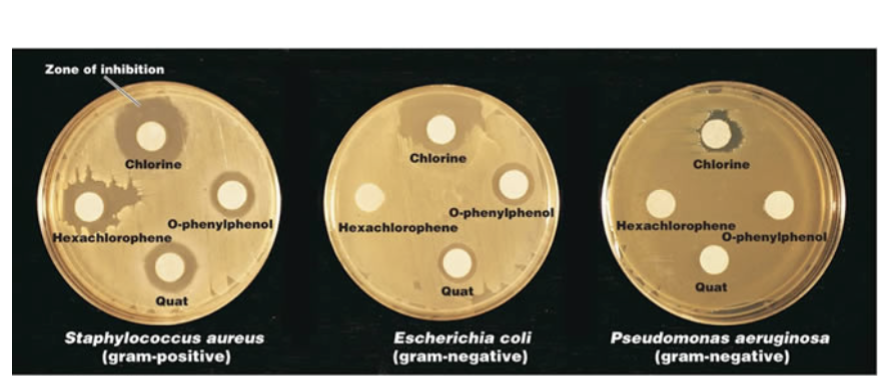
<p>Kirby-Bauer Antibiotic Sensitivity Test</p>
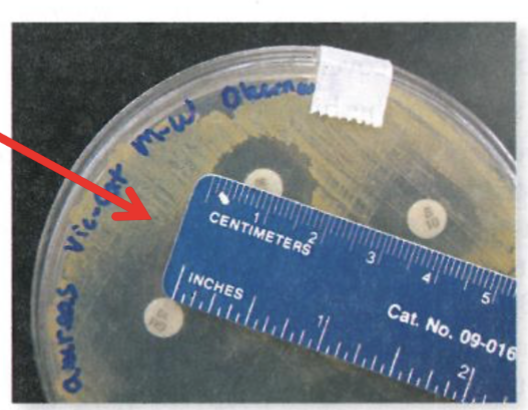
knowt flashcard image

1/30
Looks like no tags are added yet.
Name | Mastery | Learn | Test | Matching | Spaced | Call with Kai |
|---|
No analytics yet
Send a link to your students to track their progress
Round Worms
1. Cylindrical, non
segmented worms
2. Sex organs on separate
worms
3. No hooks or suckers to
attach to host
4. Inhabit the intestinal
tract, blood, organs,
tissues
Flat Worms
Flat body shape
2. May be
hermaphrodites
3. Have hooks/ suckers to
attach to host
4. Inhabit intestinal tract,
blood, organ tissues

Taenia saginata
MOT - Eating undercooked beef with cysticerci
Infective stage - Cysticerci
Hosts - D - Human, I - Cattle
Disease - Taeniasis


Taenia solium
Mode of Transmission: Eating undercooked pork with cysticerci
• Infective Stage: Cysticerci
• Hosts: D-Human, I-pig
Disease: Taeniasis

Taenia saginata

Taenia solium

Diphyllobothrium latum
Mode of Transmission: Eat fish with cysticerci
• Infective Stage: cysticerci
• Host: D- human, I-fish


Echinococcus granulosus
Mode of Transmission: Ingestion of egg/ova
• Infective Stage: Egg
• Host: D-Canine, I-human, sheep, cattle
Disease: Hydatid Cysts

Chemotherapeutic drug
Any chemical used in the
treatment, relief, or prophylaxis of a disease
Prophylaxis
use of a drug to prevent potential infection
in a person at risk
Antimicrobial chemotherapy-
the use of
chemotherapeutic drugs to control infection
Antimicrobials
any antimicrobial drug, regardless of its
origin
Antibiotic
a substance produced by microbes that can
inhibit growth or destroy other microbes
• Many synthesized antibiotics are based on natural antibiotics
Semisynthetic Drugs
compounds chemically modified in
the laboratory after being isolated from natural sources
Synthetic Drugs
compounds synthesized entirely in the
laboratory through chemical reactions
Minimum Inhibitory Concentration
Lowest concentration of an antibiotic that prevents
visible bacterial growth
• Test can be done instead of Kirby Bauer
Kirby-Bauer Method
Few antibiotics work equally well against all types of
bacteria
• Uses antibiotic containing disks to test whether
particular bacteria are susceptible to specific antibiotics
• Determines the effectiveness of multiple antibiotics at
the same time
Highly Standardized method
Kirby-Bauer Antibiotic Sensitivity Test
Standardized procedure for the Kirby-Bauer test:
Media: Mueller-Hinton agar (must be 4 mm deep)
• Media pH: 7.2-7.4
• Amount of Bacteria: 0.5 McFarland Turbidity Standard
• 150 million bacterial cells/ml of liquid
• Age of Culture for Set-up: 2-6 hours old
• Times plates are Incubated: 18-24 hours
• Temperature of Incubation: 35-37°C
• Spreading Technique: Bacterial Lawn
Kirby-Bauer Antibiotic Sensitivity Test

what does the Kirby-Bauer Antibiotic Sensitivity Test measure?
Measures the zone of inhibition (mm)
• Circular area around the antibiotic disk
• Measured Zones of Inhibition are compared to a
chart supplied by the manufacturer
• Determines if bacteria are sensitive or resistant
to the antibiotic
• All labs that do this test must follow the
same standards
Measure Diameter in Millimeters
Resistant
antibiotic has no effect on the
bacteria
intermediate
antibiotic is only moderately
effective against the bacteria
sensitive
antibiotic is effective against the
bacteria (prevents growth)
Effects of Antibiotics on Bacteria
Broad Spectrum antibiotics: Effective against a large
range of bacteria
• Example: Gram-Positive and Gram-Negative Bacteria
• Narrow spectrum antibiotics: Effective against a
small group of bacteria
• Example: Effective against only Gram-Positive Bacteria
• Bactericidal-kills bacteria
• Bacteriostatic-inhibit reproduction of bacteria,
allows immune system to eliminate them
Broad Spectrum antibiotics:
Effective against a large range of bacteria
• Example: Gram-Positive and Gram-Negative Bacteria
Narrow spectrum antibiotics:
Effective against a
small group of bacteria
• Example: Effective against only Gram-Positive Bacteria
Bactericidal
kills bacteria
Bacteriostatic
inhibit reproduction of bacteria,
allows immune system to eliminate them
General Actions of Antibiotics
Cell membrane
DNA / RNA